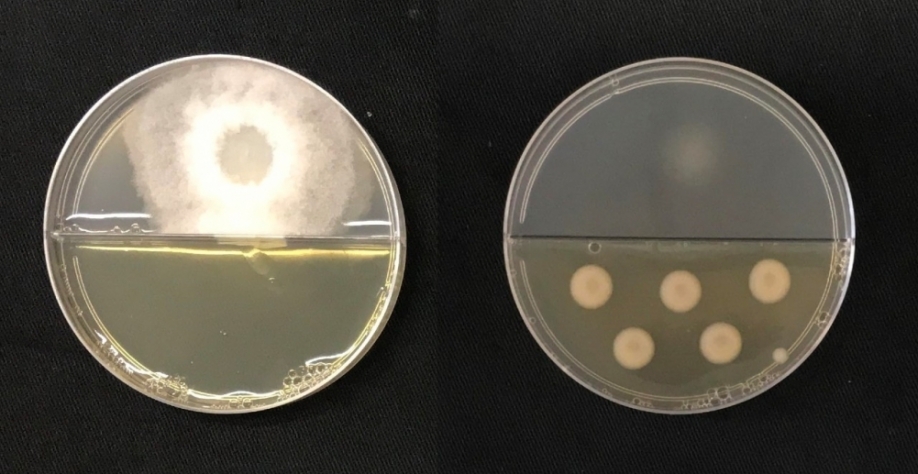
Na imagem da esquerda o fungo Thielaviopsis ethacetica cresce sem contato com os compostos orgânicos volateis (COVs) bacterianos. Já na imagem da direita o crescimento do fungo (na parte superior) foi inibido pela bactéria (na parte inferior) produtora do

Pesquisa descobre bactérias capazes de matar fungo causador de doença que reduz a produtividade da cana
17-03-2022
Estudo desenvolvido no Centro Nacional de Pesquisa em Energia e Materiais (CNPEM) descobriu três linhagens de bactérias do gênero Pseudomonas capazes de inibir o crescimento e até causar a morte do fungo responsável pela doença chamada podridão abacaxi, que ataca canaviais principalmente no período de plantio.
Por Luciana Constantino | Agência FAPESP
Os resultados do trabalho, publicados na revista científica Environmental Microbiology, da Society for Applied Microbiology, possibilitam o desenvolvimento de fungicidas biológicos como alternativa aos agrotóxicos usados atualmente contra a praga.
As três cepas das bactérias foram capazes de inibir, in vitro, até 80% do crescimento micelial do fungo Thielaviopsis ethacetica, presente no solo e que se aproveita de cortes ou ferimentos nos toletes da cana-de-açúcar para entrar na planta e reduzir em até 50% a brotação, reduzindo a produtividade. Os micélios formam a massa de ramificação, composta por um conjunto de filamentos (hifas) emaranhados, que carrega nutrientes imprescindíveis para a sobrevivência do fungo.
A pesquisa mostrou que essas bactérias produziram 62 compostos orgânicos voláteis (COVs) diferentes, que regularam negativamente os genes relacionados ao metabolismo de carboidratos, essencial para o crescimento do fungo. Os COVs são produtos decorrentes do metabolismo das bactérias, podendo ser obtidos em forma de líquidos e gases, que evaporam facilmente à temperatura ambiente. Uma das vantagens é que podem atingir longas distâncias em uma eventual aplicação em culturas.
“Pela primeira vez, vimos que a molécula atua direta ou indiretamente no DNA do patógeno, causando um dano. É um composto que quebra o DNA. Esse tipo de molécula é pouco explorado no Brasil. Nosso objetivo é nos tornarmos fortes nessa linha de pesquisa, sendo referência no estudo dessas moléculas em nosso país”, afirmou à Agência FAPESP Juliana Velasco de Castro Oliveira, pesquisadora do Laboratório Nacional de Biorrenováveis do Brasil (LNBR), do CNPEM, e coordenadora do trabalho.
O estudo recebeu o apoio da FAPESP por meio dos programas Pesquisa em Bioenergia (BIOEN) e Pesquisa em Parceria para Inovação Tecnológica (PITE).
Durante as análises transcriptômicas da resposta do fungo aos COVs (usadas para identificar e quantificar a expressão de genes novos ou previamente conhecidos) e de microscopia eletrônica, os cientistas detectaram mudanças na expressão de genes importantes, bem como alterações morfológicas críticas nos micélios tratados com COVs, comprovando seu menor crescimento e até a morte celular.
“Conseguimos encontrar cepas de bactéria eficientes no controle do patógeno que causa danos importantes na cultura da cana-de-açúcar. Também identificamos moléculas que não haviam sido descritas como tendo capacidade de matar esses fungos e comprovamos que essas moléculas conseguem causar dano ao DNA, o que é pouco documentado na literatura”, resume Oliveira.
A podridão abacaxi é uma doença que afeta diversas culturas tropicais, mas no Brasil tem impacto especialmente na produtividade do setor sucroenergético. O fungo consegue impedir a germinação de mudas ou retardar seu desenvolvimento, deixando as áreas afetadas com grandes falhas.
Conforme o fungo se reproduz no interior da planta, as fibras do caule apresentam uma coloração avermelhada, que aos poucos fica mais escura e coberta de esporos. A fermentação provocada pelo patógeno libera um odor parecido ao de abacaxi, daí o nome da doença.
Com o aumento da incidência nos últimos anos, a doença está entre as mais frequentes nos canaviais. O Brasil é o maior produtor mundial de cana-de-açúcar. Na safra 2020/21, foi responsável pela produção de 654,5 milhões de toneladas, destinadas à produção de 41,2 milhões de toneladas de açúcar e 29,7 bilhões de litros de etanol.
Algumas técnicas de manejo na época do plantio, como a seleção de mudas e cuidados na preparação do solo, ajudam a prevenir a podridão abacaxi. No entanto, para controlar a infecção, é necessário o uso de agrotóxicos, que podem gerar riscos ao meio ambiente e à saúde humana caso não sejam aplicados de maneira e na quantidade adequadas.
“O Brasil é uma potência agrícola. Sabemos que ainda não é possível fazer uma substituição completa dos pesticidas químicos por alternativas biológicas. Com novos estudos, como o nosso, essa oferta pode crescer no mercado, sendo uma alternativa sustentável e que pode ajudar a reduzir a dependência do país pela importação dos produtos”, disse a pesquisadora.
No total, o Brasil importa, por ano, mais de 330 mil toneladas de inseticidas, herbicidas e fungicidas, segundo dados do Ministério da Economia. Além disso, entre 2019 e 2021 houve a autorização de uso de pelo menos 1.500 novos pesticidas.
Novas tecnologias
Os pesquisadores iniciaram o trabalho a partir do banco de microrganismos do LNBR, que tem um acervo com cerca de 7 mil bactérias de diferentes tipos de solos e de raízes. Selecionaram 70 microrganismos de diferentes gêneros e localidades, como Tocantins, Mato Grosso e São Paulo. Essa amostra foi submetida a ensaios in vitro para avaliar a capacidade de inibir o crescimento do fungo, chegando às três linhagens do gênero Pseudomonas, que foram confirmadas por meio de sequenciamento genético.
Agora os cientistas iniciaram uma nova fase para descobrir a espécie dessas cepas. “Sabemos que elas são diferentes, mas ainda não temos certeza de quais são. Para isso, precisaremos fazer o sequenciamento total dessas bactérias. Inclusive vimos que uma delas é de uma espécie ainda não descrita. Em parceria com a Unicamp [Universidade Estadual de Campinas], vamos tentar descrevê-la em breve”, afirmou Oliveira.
Cientistas do Programa de Pós-Graduação em Genética e Biologia Molecular da Unicamp e da Universidade Federal de Lavras (MG) participam do grupo de pesquisa. “Hoje em dia não é possível fazer pesquisa sozinho, principalmente quando se está explorando uma área nova. Por isso, a importância de agrupar expertises”, completou.
No Laboratório Nacional de Luz Síncrotron (LNLS), responsável pela operação do Sirius (acelerador de partículas de quarta geração), análises por espectroscopia confirmaram a capacidade de as biomoléculas produzirem danos ao DNA do patógeno. Para revelar essa espécie de “impressão digital” das biomoléculas, foram usadas técnicas de pesquisa de alta sensibilidade com uso de infravermelho.
Além disso, no Laboratório Nacional de Nanotecnologia (LNNano), que também faz parte do CNPEM, foram utilizados recursos de microscopia de transmissão e escaneamento que mostraram as severas alterações morfológicas nos micélios.
Em 2019, outra pesquisa coordenada por Oliveira já havia apontado o potencial de bactérias para promover o crescimento de culturas agrícolas sem causar a poluição das águas e alterações prejudiciais ao próprio solo (leia mais em: agencia.fapesp.br/30884/).
O artigo Bacterial volatile organic compounds induce adverse ultrastructural changes and DNA damage to the sugarcane pathogenic fungus Thielaviopsis ethacetica pode ser lido em: https://sfamjournals.onlinelibrary.wiley.com/doi/10.1111/1462-2920.15876.





